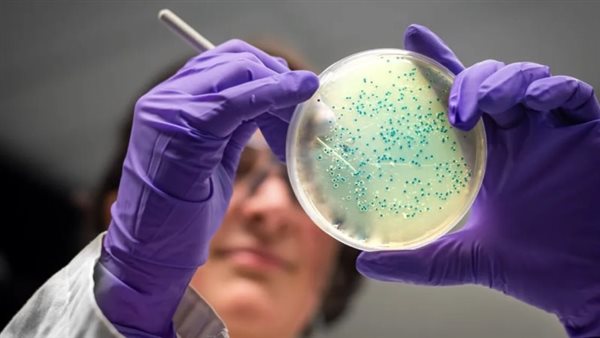
مرض الليستريا

بسبب اللحوم والجبن الملوث.. تفشي مرض الليستريا في الولايات المتحدة الأمريكية
أعلنت المراكز الأمريكية لمكافحة الأمراض والوقاية منها اليوم، أن تفشي مرض الليستريا القاتل في 6 ولايات كان مرتبطًا باللحوم والجبن الملوثة.
تفشي مرض الليستريا في الولايات المتحدة الأمريكية
وأصيب 16 شخصًا بمرض الليستريا في الولايات المتحدة، ونقل 13 إلى المستشفى في 6 ولايات، وتم الإبلاغ عن حالة وفاة واحدة في ولاية ماريلاند؛ بينما أصيبت امرأة أخرى بالمرض أثناء الحمل، وفقدت طفلها، حسب مراكز السيطرة على الأمراض.
وحتى الآن؛ تم الإبلاغ عن 6 إصابات بالليستيريا في نيويورك، 3 في ماريلاند، 2 في إلينوي، 2 في ماساتشوستس، واحدة في كاليفورنيا وواحدة في نيوجيرسي، وتراوحت أعمار المصابين بين 38 و92، بمتوسط عمر يصل إلى 74 عامًا، وكان أكثر من نصف المصابين بذلك المرض من الرجال.
وقال مركز السيطرة على الأمراض، إن معظم الأشخاص الذين تم تحديدهم في تفشي المرض حتى الآن؛ هم من أصل أوروبي شرقي أو يتحدثون الروسية، مضيفًا أنهم لا يزالون يحققون في أسباب تفشي المرض على بين سكان الولايات الأمريكية.
ونصح مركز السيطرة على الأمراض، الأشخاص المُعرضين لخطر الإصابة بمرض شديد من عدوى الليستريا مثل الحوامل وكبار السن وذوي الجهاز المناعي الضعيف، بعدم تناول اللحوم أو منتجات الجبن الجاهزة.
من هم الأكثر عرضة لإصابة بـ مرض
يعد مرض الليستريا؛ السبب الرئيسي الثالث للوفاة من التسمم الغذائي في الولايات المتحدة، وهو خطير بشكل خاص لأي شخص أكبر من سن الـ 65 عامًا، والأشخاص الذين يعانون من ضعف في جهاز المناعة أو النساء الحوامل، وفقًا لمركز السيطرة على الأمراض.
ويتعرض الأشخاص الحوامل لخطر الإصابة بمرض الليستريا بشكل خاص، حيث تعد النساء الحوامل؛ أكثر عُرضة للإصابة بعدوى الليستريا بـ 10 مرات من الرجال، ويمكن أن يتعرض الأطفال حديثي الولادة المصابون بمرض الليستيريا، بعدوى الدم والتهاب السحايا ومضاعفات أخرى خطيرة.





















